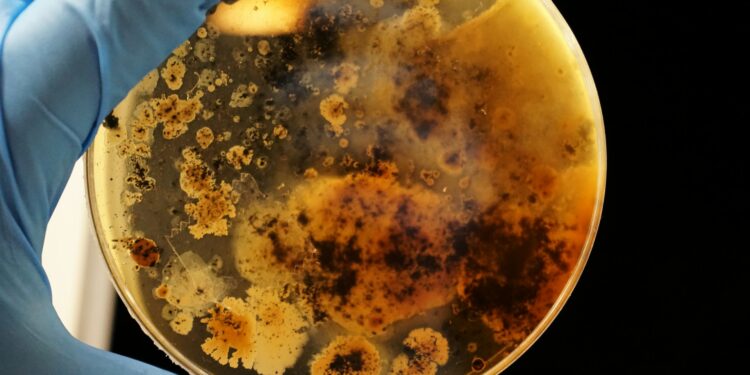
Επιστήμονες ανακάλυψαν «ανθεκτικό» βακτήριο με «μοναδικές ιδιότητες» στον κινεζικό διαστημικό σταθμό

Ένα εξαιρετικά ανθεκτικό και μυστηριώδες βακτήριο με «μοναδικές ικανότητες» ανακαλύφθηκε στον κινεζικό Διαστημικό Σταθμό Tiangong, προσφέροντας νέες γνώσεις στους επιστήμονες σχετικά με την εξέλιξη της ζωής σε διαστημικές συνθήκες και τη σημασία της για τις μελλοντικές επανδρωμένες αποστολές.
Το νέο βακτήριο, με την ονομασία «Niallia tiangongensis», απομονώθηκε από «την επιφάνεια του εξοπλισμού στον Κινεζικό Διαστημικό Σταθμό» από Κινέζους αστροναύτες στο πλαίσιο του προγράμματος CHAMP (China Space Station Habitation Area Microbiome Program), σύμφωνα με μελέτη του Ινστιτούτου Μηχανικής Διαστημοπλοίων του Πεκίνου, η οποία δημοσιεύθηκε στο International Journal of Systematic and Evolutionary Microbiology.
Το Niallia tiangongensis είναι στενός συγγενής του Niallia circulans, το οποίο εντοπίζεται στη Γη σε χώματα, λυμάτων και ανθρώπινες ακαθαρσίες, όμως διαθέτει «πολλαπλές μεταλλάξεις που θα μπορούσαν να είναι χρήσιμες στη μελέτη της ζωής στο διάστημα», όπως αναφέρεται στη μελέτη.
Οι επιστήμονες σημειώνουν ότι το νέο στέλεχος «έχει τη μοναδική ικανότητα να υδρολύει ζελατίνη, υποδήλωνοντας ότι μπορεί να την χρησιμοποιεί ως υπόστρωμα σε περιβάλλοντα με περιορισμένα θρεπτικά συστατικά».

Επιπλέον, το Niallia tiangongensis παρουσίασε «δομικές και λειτουργικές διαφορές σε δύο σημαντικές πρωτεΐνες», γεγονός που, σύμφωνα με τη μελέτη, «μπορεί να βελτιώσει τον σχηματισμό βιομεμβρανών, την αντίσταση στο οξειδωτικό στρες και την αποκατάσταση από ακτινοβολία».
Όλες αυτές οι μοναδικές ιδιότητες, πιθανή συνέπεια των μεταλλάξεων κατά την παραμονή του στη διάστημα, καθιστούν το Niallia tiangongensis εξαιρετικά ανθεκτικό και προσαρμοστικό σε διαστημικά περιβάλλοντα, σύμφωνα με την επιστημονική έκθεση.
Η απομόνωση του βακτηρίου έγινε το 2023 με μια απλή μεθοδολογία: οι «ταϊκοναύτες» που χρησιμοποιήθηκαν αποστειρωμένα πανάκια για να σκουπίσουν τις επιφάνειες του σταθμού και μετέφεραν τα δείγματα πίσω στη Γη, σύμφωνα με τη South China Morning Post.
Το πρόγραμμα CHAMP ανακαλύπτει τη μικροβιακή δυναμική σε συνθήκες μακροχρόνιας παραμονής στο διάστημα και εστιάζει στη μελέτη βιοδραστικών ουσιών, γενετικών πόρων και μεταβολικών λειτουργιών των μικροοργανισμών.
Η γνώση που προκύπτει από αυτές τις μελέτες θεωρείται κρίσιμη για τις μελλοντικές επανδρωμένες αποστολές μεγάλης διάρκειας, ενώ μπορεί να έχει εφαρμογές και στην ιατρική και γεωργία, όπως σημειώνεται στην έκθεση.
Η New York Post αναφέρει ότι και στον Διεθνή Διαστημικό Σταθμό (ISS) εντοπίστηκε πρόσφατα ένα παρόμοιο ανησυχητικό εύρημα: μια μελέτη που δημοσιεύτηκε πέρυσι αποκάλυψε ότι Αμερικανοί αστροναύτες είχαν ανακαλύψει μια μεταλλαγμένη και ανθεκτική στα φάρμακα έκδοση ενός κοινού βακτηρίου που συναντάται συχνά στο ανθρώπινο γαστρεντερικό σύστημα.